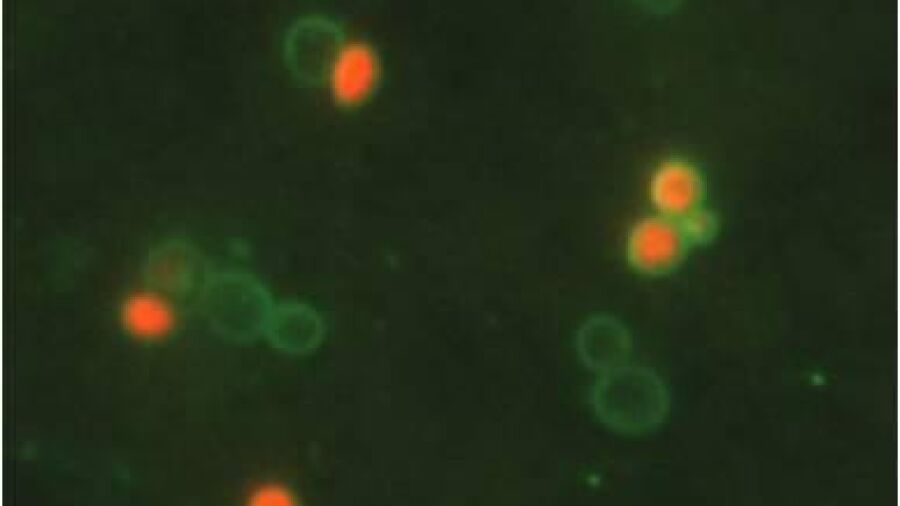
Nieuwe methode geeft snelle indicatie aanwezigheid legionella

Nieuwe methode geeft snelle indicatie aanwezigheid legionella
Adviesbureau Hydroscope uit Breda heeft een methode ontwikkeld om in twee uur vast te kunnen stellen of in een een watermonster levende legionellabacteriën zitten. Dat is veel sneller dan met de officieel toegelaten kweekmethode, die bijna een week in beslag neemt.
Het adviesbureau uit Breda vraagt eigenaren van drinkwaterinstallaties met legionellaproblemen te helpen met de validatie van de nieuwe methode. De methode geeft uitsluitsel over legionella via een geprepareerd drinkwatermonster en een automatische fotomicroscoop.
Oscar Nuijten van installateursdenktank Isso uit Rotterdam waarschuwt dat de kweekmethode vooralsnog de enige toegelaten methode is om officieel legionella vast te stellen in prioritaire instellingen als ziekenhuizen, hotels en zwembaden. “Hydroscope mag zijn methode wel gebruiken om een opdrachtgever snel te kunnen informeren over een eventuele besmetting.”





